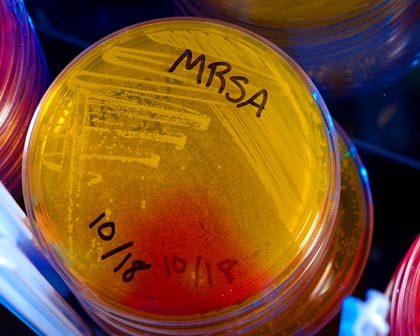
MRSA & MJ

We find a moderate correlation between the genetic structure of marijuana strains and their reported sativa and indica ancestry and show that marijuana strain names often do not reflect a meaningful genetic identity...... More
Although uncommon, allergic disease associated with C sativa exposure and use has been reported with increased frequency..... More
A compelling argument that eCB signaling is an important regulatory system in the brain that largely functions to buffer against many of the effects of stress.... More
The endocannabinoid system is an essential regulator of bodily function in its many facets. There is hardly any physiological process that is not affected by it. More
Demonstrates that targeted dietary manipulation can alter eCS derived from omega-3 and omega-6 fatty acids in humans, and could have pain modulating properties. More
As states legalize the production of cannabis, regulations governing its cultivation may allow the application of pesticides untested for use in the plant’s production, raising safety issues. More
Undoubtedly, cannabis biotechnology will be crucial to delivering medical and recreational needs for millions of people. More
Get better information on when it is legal for you to drive... More
The plant Cannabis sativa and its many preparations (for example, marijuana, hashish, bhang and ganja) have been used for millennia. More
The plant Cannabis sativa and its many preparations (for example, marijuana, hashish, bhang and ganja) have been used for millennia. More
Anti-depressant effects marijuana, hashish, bhang and ganja) have been used for millennia. More
Humans may have cultivated cannabis for longer than any other plant.It has been grown for 12,000 years. More
NSAIDs, Opioids, Cannabinoids and the Control of Pain by the
Central Nervous System. More
Michael Backes author of the book Cannabis Pharmacy Watch on Youtube
The following standards of identity, analysis and quality control of Cannabis are intended to provide scientifically valid methods for the analysis of cannabis and its preparations. More
Marijuana users had a lower age-adjusted prevalence of DM compared to non-marijuana users - in this study of 10,896 patients. More
Recoveries of residues were as high as 69.5% depending on the device used... component investigated, suggesting that the potential of pesticide and chemical residue exposures to cannabis users is substantial. More
Cannabis, the ancient mutliuse genus, is one of Homo sapiens' most favored yet controversial plant allies. More
These compounds exhibit promising in vitro and in vivo biological activities, but are still waiting clinical trials. More
Our objective was to determine the short-term effect of smoked cannabis on spasticity symptoms. More
"I believe that medical marijuana as a therapeutic entity is here to stay. It is being used in numerous medical conditions, at times with considerable success. Are we entitled to neglect a valuable drug?" More
To determine the association between diabetes mellitus (DM) and marijuana use and Marijuana users had a lower age adjusted prevalence of diabetes compared to non-marijuana users. More
In a clinical study with 279 patients suffering from multiple sclerosis a cannabis extract improved muscle stiffness,pain, spasms and sleep. More
Examining the science of cannabis and cannabinoids without the politics. More
The ability of D9-THCV to reduce motor inhibition and provide neuroprotection was investigated. More
Marijuana extracts kill antibiotic-resistant MRSA without a high. More
research on the role of the endocannabinoid system in gut function and dysfunction has received ever increasing attention since the discovery of the ECS. More
endocannabinoids and their receptors have emerged as major regulators of several pathophysiological aspects associated with chronic liver disease progression. More
Moreover, cannabinoids were also able to inhibit tumor growth. More
Results of this study show that Δ9-THC and other cannabinoids exert antidepressant-like actions, and thus may contribute to the overall mood-elevating properties of cannabis. More
Scientific evidence is presented for non-cannabinoid plant components as putative antidotes to intoxicating effects of THC that could increase its therapeutic index. More
Scientific evidence is presented for non-cannabinoid plant components as putative antidotes to intoxicating effects of THC that could increase its therapeutic index. More
research into the CB2 receptor as a possible target for the treatment of neuroinflam-matory and neuro-degenerative disorders (eating disorders, depression and schizophrenia). More
Cannabis has been used to treat gastrointestinal (GI) conditions that range from enteric infections and in flammatory conditions to disorders of motility, emesis and abdominal pain. More
Research on the chemistry and pharmacology of cannabinoids and endocannabinoids. More
Clinical studies largely affirm that neuropathic pain patients derive benefits from cannabinoid treatment. More
Marijuana (Cannabis satiVa) has long been known to contain antibacterial cannabinoids, whose potential to address antibiotic resistance has not yet been investigated. More
The discovery of cannabinoid receptors, their endogenous ligands, and the machinery for the synthesis, transport, and degradation of these retrograde messengers, has equipped us with neurochemical tools for novel drug
design. More
This study examines the current knowledge of physiological and clinical effects of tetrahydrocannabinol (THC) and cannabidiol (CBD) and presents a rationale for their combination in pharmaceutical preparations. More
We provide a comprehensive overview on the current state of knowledge of the endocannabinoid system as a target of pharmacotherapy. More
Here, we studied the effect of cannabidiol, a major non-psychoactive component of the marijuana plant on alzheimer's disease. More
Can this explain therapeutic benefits of cannabis in migraine, fibromyalgia, irritable bowel syndrome. More
Our results indicate that the endogenous cannabinoid system represents a promising therapeutic target for the treatment of intestinal disease conditions characterized by excessive inflammatory responses. More
It is appropriate that modern-day cannabinoid researchers have acknowledged the integral role that Indian culture has played in our understanding of the biochemistry of cannabis. More